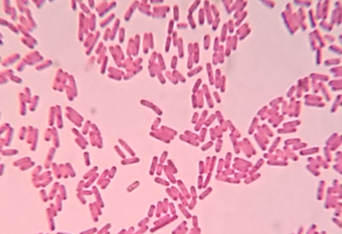

Supreet Saini
Core Faculty
Professor

1, 2nd Floor CESE-DESE
Core Faculty
Professor
Intermediate Fellow, DBT-Wellcome Trust (India Alliance) (2020)
Young Associate Indian National Academy of Engineers (INAE) (2016)
Innovative Young Biotechnologist Award Department of Biotechnology (2010)

There are more than 10 million species of complex life forms on Earth. We are intrigued that there are so many species around and work towards understanding why speciation is/might be a necessary evolutionary process. Our group uses experiments and theory to work on the following questions. In this context, we study why concrete barriers to gene flow are necessary, and why varieties of life forms will not suffice? Or, is speciation merely a fall out of an adaptive process? Where do species come from? What are the properties of an environment and/or the genetic make up of a population which allows the population of a single species to split into two distinct species? We are particularly interested in addressing the process of speciation, while gene flow between individuals is permitted.
A number of species coexist in an ecological niche. This coexistence is difficult to explain in the face of Darwinian “survival of the fittest” which dictates that given an environment, only the best adapted to survive in the environment thrive, while all others go extinct. What are the additional forces acting between individuals and between individuals & the environment which facilitate coexistence of multiple species is a question of interest in our group. We use bacterial communities isolated from soil samples to address this question.

Multiple evolutionary experiments in literature have suggested that given an environmental challenge, multiple adaptive paths exist which help the population to survive and increase its fitness. However, should the environmental challenge be reversed, would the adaptive path be reversed, or do alternate pathways exist for the population to reverse its phenotype, is a question which has remained largely unexplored. In this research, we study reversibility of evolutionary processes in the context of speciation, evolution of cooperation & conflict, and role of epistasis in dictating evolution.